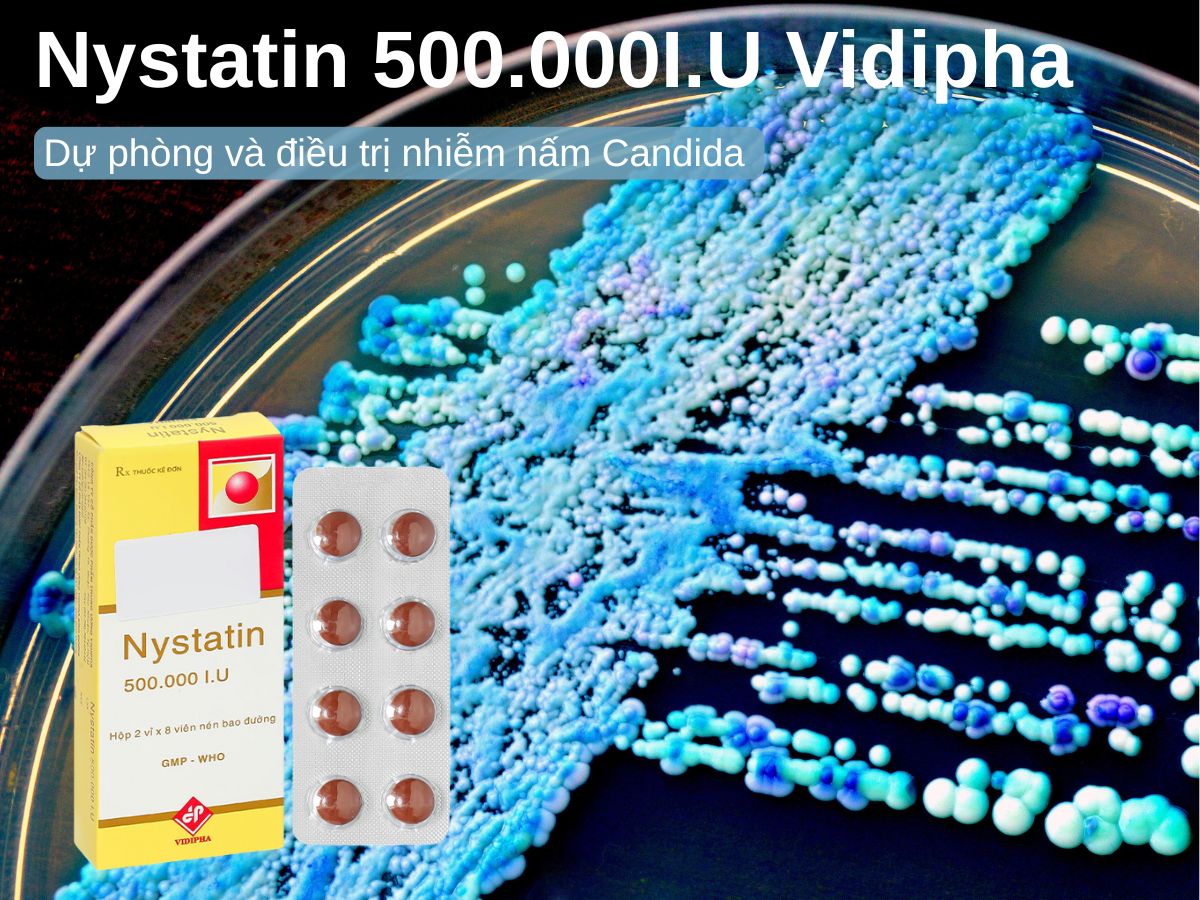

Trong bài viết này, dược sĩ Lưu Văn Hoàng giới thiệu đến các bạn thuốc Nystatin 500.000I.U Vidipha được sản xuất bởi Công ty cổ phần dược phẩm Trung ương Vidipha có số đăng ký lưu hành tại Việt Nam là 893110271200 (SĐK cũ: VD-24878-16)
Nystatin 500.000I.U Vidipha là thuốc gì?
Thành phần
Trong mỗi viên uống Nystatin 500.000I.U Vidipha có chứa:
- Nystatin……………………………..500.000 IU.
- Tá dược: lactose, PVP K30, bột talc, magnesi stearat, aerosil, đường trắng, gôm arabic, gelatin, titan dioxyd, sáp ong, sáp carnauba, màu yellow sunset, màu oxyd sắt đỏ, màu oxyd sắt nâu.
Dạng bào chế: Viên bao đường
Trình bày
SĐK: 893110271200 (SĐK cũ: VD-24878-16)
Quy cách đóng gói: Hộp 2 Vỉ x 8 Viên
Xuất xứ: Việt Nam
Hạn sử dụng: 36 tháng
Tác dụng của thuốc Nystatin 500.000I.U Vidipha
Cơ chế tác dụng
Nystatin thuộc nhóm kháng sinh có tác dụng chống nấm, được phát hiện và tách chiết từ loài nấm Streptomyces noursei. Thuốc gắn vào sterol trong màng tế bào nấm, gây thay đổi tính thấm, làm rò rỉ thành phần nội bào và tiêu diệt nấm. Nystatin tác động chủ yếu trên các loài nấm men, đặc biệt hiệu quả với Candida albicans. Thuốc không ảnh hưởng đến vi khuẩn thường trú.
Đặc điểm dược động học
Nystatin hầu như không hấp thu qua đường tiêu hóa, da và niêm mạc.
Khi dùng đường uống, thuốc được đào thải chủ yếu qua phân ở dạng chưa chuyển hóa.
Do đặc tính này, thuốc chỉ có hiệu quả tại chỗ trong đường tiêu hóa và không dùng để điều trị nấm toàn thân.
Thuốc Nystatin 500.000I.U Vidipha được chỉ định trong bệnh gì?
Điều trị và dự phòng nhiễm nấm Candida tại đường tiêu hóa.
Hỗ trợ phòng ngừa Candida ruột ở bệnh nhân đang điều trị bằng kháng sinh phổ rộng.
Liều dùng và cách sử dụng
Liều dùng
Điều trị nhiễm Candida đường ruột hoặc thực quản: 500.000 – 1.000.000 IU/lần, dùng 3 – 4 lần/ngày.
Dự phòng ở bệnh nhân dùng kháng sinh phổ rộng: 1.000.000 IU/ngày.
Cách sử dụng
Uống trực tiếp viên nén Nystatin 500.000I.U Vidipha theo đường tiêu hóa.
Thuốc chỉ dùng cho người lớn, tuyệt đối không dùng cho trẻ nhỏ.
Không sử dụng thuốc Nystatin 500.000I.U Vidipha trong trường hợp nào?
Người có tiền sử quá mẫn với Nystatin hay tá dược có trong Nystatin 500.000I.U
Lưu ý đặc biệt khi sử dụng thuốc
Thận trọng
Thuốc có chứa lactose và đường, do đó cần cân nhắc trước khi sử dụng cho người bị tiểu đường hoặc không dung nạp lactose, vì có thể làm nặng thêm tình trạng bệnh.
Người bệnh nếu có dấu hiệu mẫn cảm, dị ứng trong quá trình dùng thuốc (ví dụ: nổi mẩn đỏ, ngứa, khó chịu) thì nên ngưng thuốc ngay và liên hệ với nhân viên y tế để được xử trí thích hợp.
Thuốc không có hiệu quả trong điều trị nấm toàn thân, bởi dược chất gần như không hấp thu qua đường tiêu hóa. Vì vậy chỉ nên dùng cho các trường hợp nhiễm nấm tại chỗ ở niêm mạc ruột.
Tác dụng phụ
Ít gặp (1/1000 < ADR < 1/100): buồn nôn, có thể nôn, rối loạn tiêu hóa, tiêu chảy; nổi mày đay, ban đỏ trên da.
Hiếm gặp (<1/1000): kích ứng nhẹ tại vùng sử dụng thuốc, hội chứng Stevens–Johnson
Nhìn chung, thuốc dung nạp tốt ngay cả khi sử dụng dài ngày.
Tương tác
Khi dùng đồng thời với riboflavin phosphat, hiệu quả kháng nấm Candida albicans của thuốc có thể giảm đáng kể.
Cần tránh kết hợp với các thuốc làm thay đổi nhu động ruột hoặc những loại có tác dụng bao phủ niêm mạc tiêu hóa, vì có thể làm giảm khả năng tiếp xúc của Nystatin với nấm gây bệnh, từ đó làm giảm hiệu lực điều trị.
Lưu ý cho phụ nữ có thai và cho con bú
Phụ nữ mang thai: chỉ nên dùng thuốc khi bác sĩ đánh giá lợi ích cho mẹ khi dùng Nystatin cao hơn nguy cơ tiềm ẩn đối với thai nhi. Việc tự ý sử dụng trong thai kỳ là không khuyến khích.
Phụ nữ cho con bú: hiện chưa có dữ liệu khẳng định Nystatin có bài tiết vào sữa mẹ hay không. Vì thế, cần hết sức thận trọng, chỉ sử dụng khi thật sự cần thiết và có sự hướng dẫn của bác sĩ.
Lưu ý khi sử dụng cho người lái xe và vận hành máy móc
Cho đến nay, chưa có báo cáo nào ghi nhận thuốc gây ảnh hưởng đến khả năng lái xe hoặc điều khiển máy móc.
Tuy vậy, người dùng vẫn nên lưu ý nếu xuất hiện bất kỳ tác dụng phụ nào gây khó chịu hoặc ảnh hưởng đến sự tập trung, cần tạm ngừng các hoạt động này và tham khảo ý kiến thầy thuốc.
Quá liều và xử trí
Biểu hiện khi dùng quá liều: Người bệnh có thể gặp phải các rối loạn tiêu hóa như cảm giác buồn nôn, nôn ói nhiều lần, đau quặn bụng hoặc tiêu chảy kéo dài. Các dấu hiệu này thường liên quan đến việc dùng liều cao vượt quá khuyến cáo.
Cách xử trí: Khi có nghi ngờ hoặc xác định đã uống quá liều, cần đưa bệnh nhân đến cơ sở y tế càng sớm càng tốt để được thăm khám. Bác sĩ có thể áp dụng các biện pháp như làm sạch đường tiêu hóa (ví dụ rửa dạ dày khi cần), điều trị triệu chứng để giảm khó chịu và tiến hành các biện pháp hỗ trợ toàn trạng nhằm phòng ngừa biến chứng.
Bảo quản
Giữ Nystatin 500.000I.U Vidipha ở nơi khô ráo, thoáng mát (<30℃), tránh ánh nắng quá mạnh từ mặt trời
Không để Nystatin 500.000I.U Vidipha trong tầm với trẻ em
Không sử dụng Nystatin 500.000I.U Vidipha khi quá hạn cho phép
Sản phẩm tương tự
Quý khách có thể tham khảo các sản phẩm khác của nhà thuốc có cùng hoạt chất và tác dụng với Nystatin 500.000I.U Vidipha như:
Nystatab có thành phần chính là Nystatin 500.000 IU, được sản xuất bởi công ty cổ phần dược phẩm Agimexpharm, điều trị và phòng ngừa nhiễm nấm Candida đường tiêu hóa.
Gentusi có thành phần chính là Nystatin, Metronidazol, Cloramphenicol,…được sản xuất bởi LTD Farmaprim, điều trị và phòng ngừa nhiễm nấm Candida đường tiêu hóa.
Tài liệu tham khảo
- Tờ Hướng dẫn sử dụng thuốc Nystatin 500.000I.U Vidipha được Bộ Y tế phê duyệt. Xem và tải về bản PDF đầy đủ tại đây. Truy cập ngày 3 tháng 10 năm 2025
- Rai A, Misra SR, Panda S, Sokolowski G, Mishra L, Das R, Lapinska B (2022). Nystatin Effectiveness in Oral Candidiasis Treatment: A Systematic Review & Meta-Analysis of Clinical Trials. Life (Basel). Truy cập ngày 3 tháng 10 năm 2025 từ: https://pmc.ncbi.nlm.nih.gov/articles/PMC9697841/
































Bình An –
dược sĩ tư vấn nhiệt tình